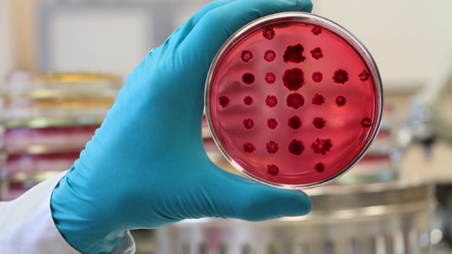
featured

Isamar Castillo R (52)
22. USB. Estudiante de Biología. No soy ni lo que vez ni lo que lees y a la vez soy todo eso.
318 followers52 posts57 following14 HP
Blacklisted UsersMuted UsersFollowed BlacklistsFollowed Muted Lists
Blacklisted UsersMuted UsersFollowed BlacklistsFollowed Muted Lists
Caracas/Venezuela Joined December 2017 Active 7 years ago